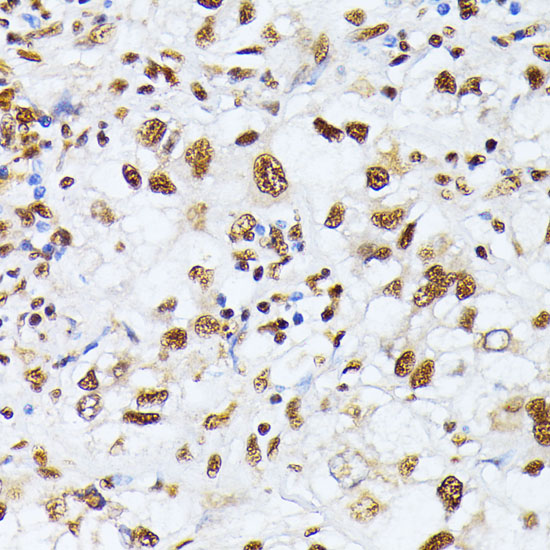

Nucleophosmin (NPM1) Rabbit Polyclonal Antibody
Other products for "NPM1"
Specifications
| Product Data | |
| Applications | IF, IHC, IP, WB |
| Recommended Dilution | WB,1:500 - 1:2000 IHC,1:50 - 1:200 IF,1:50 - 1:200 IP,1:50 - 1:200 |
| Reactivities | Human, Mouse, Rat |
| Host | Rabbit |
| Isotype | IgG |
| Clonality | Polyclonal |
| Immunogen | Recombinant protein of human NPM1. |
| Formulation | Buffer: PBS with 0.02% sodium azide,50% glycerol,pH7.3. |
| Concentration | lot specific |
| Purification | Affinity purification |
| Conjugation | Unconjugated |
| Storage | Store at -20℃. Avoid freeze / thaw cycles. |
| Stability | Shelf life: one year from despatch. |
| Predicted Protein Size | 28kDa/29kDa/32kDa |
| Gene Name | nucleophosmin (nucleolar phosphoprotein B23, numatrin) |
| Database Link | |
| Background | This gene encodes a phosphoprotein which moves between the nucleus and the cytoplasm. The gene product is thought to be involved in several processes including regulation of the ARF/p53 pathway. A number of genes are fusion partners have been characterized, in particular the anaplastic lymphoma kinase gene on chromosome 2. Mutations in this gene are associated with acute myeloid leukemia. More than a dozen pseudogenes of this gene have been identified. Alternative splicing results in multiple transcript variants. |
| Synonyms | B23; MGC104254; NPM; Numatrin |
| Reference Data | |
Documents
| Product Manuals |
| FAQs |
| SDS |
{0} Product Review(s)
0 Product Review(s)
Submit review
Be the first one to submit a review
Product Citations
*Delivery time may vary from web posted schedule. Occasional delays may occur due to unforeseen
complexities in the preparation of your product. International customers may expect an additional 1-2 weeks
in shipping.






























































































































































































































































 Germany
Germany
 Japan
Japan
 United Kingdom
United Kingdom
 China
China